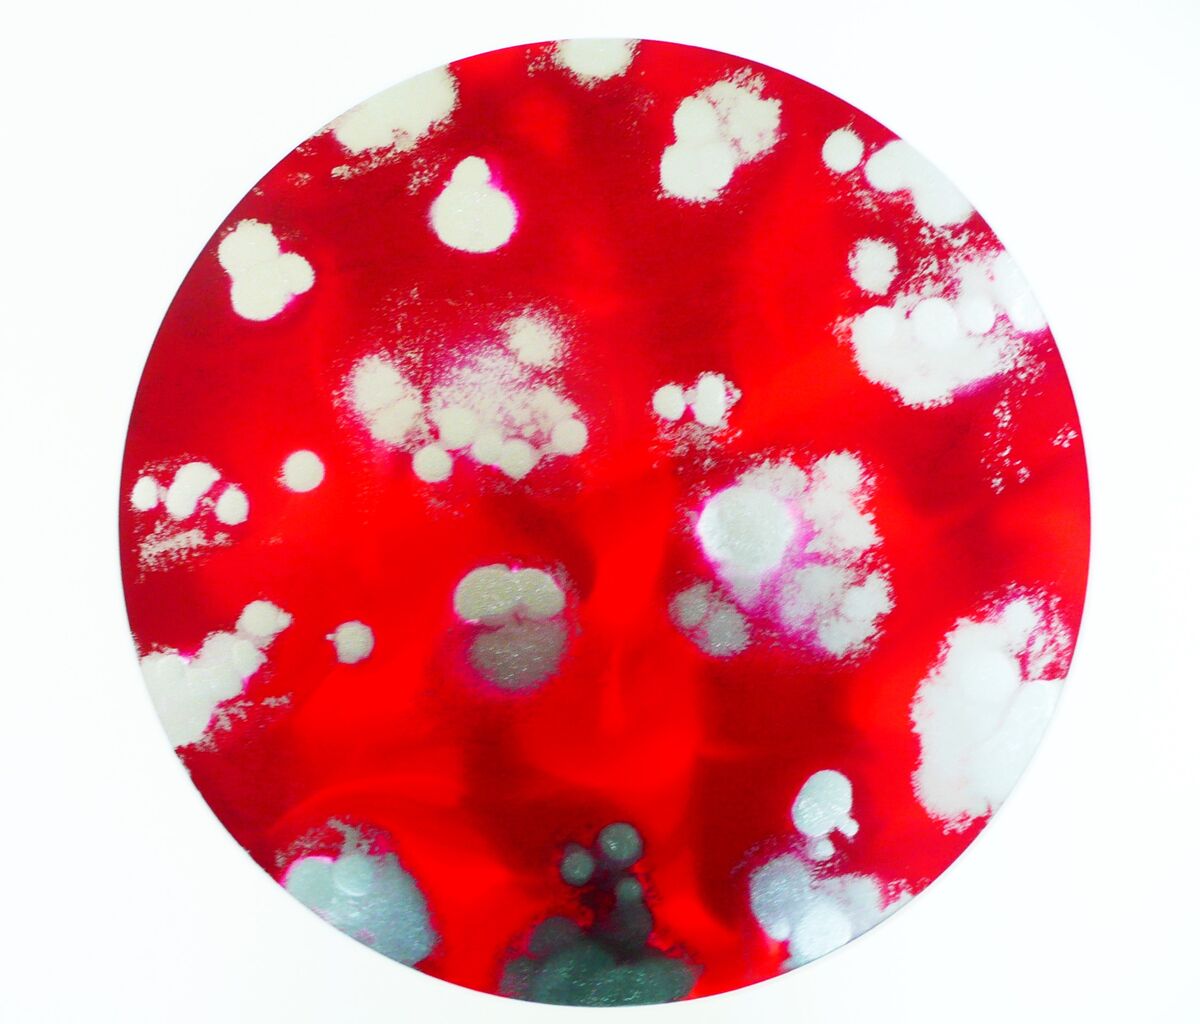

French Vineyards in Provence 48 by 24 on slim linen canvas sold arts2arts oct 2024

detail of highlanders on the loch


Deep red poppy meadow 48 /24

Tuscan hills 36 /24

brixham harbour 16/20

murano 48 /20

peonies and violets 36 /24 oil on canvas 650 lesleyblackburnart.myshopify.com

Peonies 16 by 20 Deep boxed canvas sold om artsy

Sweet Mallows Sold today lesleyblackburnart.myshopify.com

Gardenia 47 by 20 slim canvas

golden sunflowers 2026 gold leaf 1250

venetian blue 14 by 18 200 pounds sold fineartcollective.uk

Lemons in Frame oil painting on canvas

Spring Daffodils 14 by 18 inches sold in gomshall

Piccadilly circus oil on canvas 16 by 20

grand canal venice impressionistic 24 by 30 slim canvas 495

new version of lavender in provence 24 by 36 oil painting

autumn flowers 48/24 495 sold artfinder

olive grove 24 by 24 425

bluebells 48 by 40 deep boxed canvas . oil painting 950 sold om my website lesleyblackburnart.myshopify.com

fishermans cove beautiful panoramic seascape on linen canvas 16 by 32 40/80 cm

The Stag . oil painting on deep boxed canvas . 36 by 24 60 cm by 90 700.00 pounds

Londoners in the Rain . London scene with big ben . oil on linen canvas 350 pounds 16 by 22 inches 40 cm by 55 cm just sold on artsy.net first sale with artsy and opulent art

Blue Irises . Oil painting in impressionistic style on linen canvas . 35 by 24 700 .00 pounds

The Grand Canal Venice oil on linen . For sale in bobcatgallery Putney London 700 .oo 24.36 inches
NAautumn pears not avail;able

santa caterina lemons oil painting on fine linen canvas 30 by 24 inches

Christmas Shopping 40 cm by 50 cm linen canvas 300.00

Large impressionistic oil painting on deep boxed canvas . Painted sides and ready to hang .deeply textured with oils ,oil sticks and impasto painting 59 by 39 150 cm by 100 cm

Cherry blossom Large oil painting on bespoke fine linen . 48 by 20 Deep boxed . in corner gallery now

Bluebelles 48 by 40 .Large oil painting on deep boxed canvas

oceans breath 47 by 20 deep boxed canvas on fine linen aluminium frame .in corner gallery now

red poppy meadow 38 inches by 24 deep boxed canvas sold

st tropez marina 120 /50 cm 325.00 sold in guildford acvr

The lily pond going to bobcat for sale in putney

Large contemporary abstract 40 /48 sold private customer

autumn sunflower meadow panoramic 48 /24 475 .00 sold

last days of summer oil painting 120 cm by 50 cm 475.00 sold

olive grove 24 by 24 inches deep boxed canvas

piccadilly circus small painting going to bobcat

afternoon tea

summer waterlilies 2025 large painting 64 by 39 800 sold
liliac waterlilies large oil painting 64 by 39 1250 pounds not for sale

afternoon tea 32 by 24 450 pounds oil on hessain canvas

Tuscan Farmhouse 32 by 24 on hessain canvas 450 sold

The Lily Pond , Very Large painting in oils and oil sticks 64 by 39 inches

Wild poppy Meadow Large drip painting in acrylics an enamel 40 by 20 on slim canvas 550

summer waterlilies

Autumn Pear Still life 24/32 275 poi

cherry blossom lane 39 by 47 inches 750

lavender in Provence 2025 Large landscape oil painting 950 sold

Seaspray 36 by 24 inches on slim linen canvas 600 .00 sold

wild sunflower meadow 48 by 24 inches deep boxed canvas sold

coastal walk pretty scene 24 by 32 slim linen canvas sold

sunrise over north york moors 48/40 950 pounds sold to usa

summer bouquet abstract floral 28 /28 550 pounds

Lavender fields 2025 24 by 36 inches slim linen canvas

sweet violets 16 /20 150 pounds

lavender fields detail

24 by 36 slim linen canvas

wildflowerdaisy meadow 20 by 40 deep boxed canvas 650

wildirismeadow 24 by 48 deep boxed canvas 750

sicilan lemons 2025 32/32 deep boxed canvas sold

Venetian Canal 2025 40 /48 Deep boxed canvas sold to italian customer

Daisy Chain 12 /48 Deep boxed canvas Mixed Media , Oils , Sequins,enamels sold

Daisy chain . 12 by 48

river walk 20 by 24 slim linen canvas sold

blue waterlilies 39 by 32 oil on canvas 700 .00 sold to private customer

Spanish Sunflowers . New Painting 40 /40 Deep boxed canvas sold

Aubergine 70 cm by 70 cm Deep boxed canvas sold art2arts

Midsummer Night Dream 64 by 39 inches

Sunrise over North York Moors 48 by 36 inches

Wild Tulip Meadow 59 by 20 slim canvas

TULIP MEADOW 48 BY 24 INCHES mixed media sold in guildford wit acvr markets

New York Large abstract inspired by Jackson Pollock 47 by 39 deep boxed canvas

Sunflowers Fields 2025 sold with art2arts

Bluebells 2025 Contemporary Woodland scene Mixed media 24 by 36 sold

Venetian Sunset 39 /32 deep boxed canvas sold

Tulips in Vase 2025 20 by 28 slim canvas sold

wild irises 2025 40 /32 acrylic and enamel on canvas sold

sunflowers in a vase sold

sunflowers full image


rainforest abstract 32 /32 deep boxed canvas

rapeseed fields landscape on slim canvas 20 by 28 inches sold with corner gallery april 2025

GONDOLAS 2025 OIL ON CANVAS

lavender Bell abstract floral 90 cm by 60 cm deep boxed canvas not available

Lemons in Blue Vase 50 cm by 60 cm /20/24 inches fine linen canvas sold in gomshall today 18th oct

Midsummer Night Spectacular Large Painting 64 by 39 inches

section of midsummer night

section of midsummer night

section of midsummer night

Rose Garden 2025 39 /39 Deep boxed canvas . Oil painting

Pale Blue Waterlilies 2025 Beautiful Tones in Monet style. impressionistic oil on fine linen canvas 48 by 32 slim canvas

Crimson Flowers Deep boxed canvas 28 /28 inches /70 cm by 70 cm sold

SPRING BLOSSOM 120 CM BY 100 CM bobcatgallery

rainy afternoon in venice 32 /32 495.00

Winter Fruits Beautiful still life pears ,plums,apricots,cherries and blackberries in silver tankard 70 cm by 60 cm 28 /24 on deep boxed canvas very subtle lilac and pink background

impressionistic waterlily painting ,bright and textured 40 by 30 deep boxed canvas
SOLD TO UNITED STATES LAST SALE OF 2024

garden roses 20 by 20 deep boxed canvas in corner gallery SOLD ART2ARTS

Reach for the clouds 48 by 36 inches 900 sold artfinder

seashore 16 by 22 oils , inks sold

Bermuda 12 by 12 Diameter yupo paper with inks on mounted slip 110 .00 sold

Deep Purple . mounted on yupo paper . painted with inks
ink bouquet 16 by 22

Fragrant Blooms 32 by 40 deep boxed canvas sold

Disco vibes yupo paper /inks mounted slip 110

raspberry ripple inks on yupo paper mounted slip
red dragon inks on yupo paper .mounted slip

shell inks on yupo paper , mounted slip 110 pounds sold

studio image of new artworks great christmas presents

starry starry night 795 47 by 39 inches

venetian gondolas 2024 140 cm by 80 cm

The Peacock 39 by 30 inches Oils and inks

lavender fields 30 by 40 slim linen canvas sold

Bluebelle Woods 40 by 32 deep boxed canvas 725 corner gallery sold

gyspy girl 25 by 35 275

Enchanted Forest 40 /40 sold with art2arts

sunflowers in vase 40 by 40 sold with art2ats november 2024

sweet pansies 16 by 20 linen canvas 175 .00

venetian canal 20 by 28 linen canvas 275 .00 sold with art2arts

sicilian oranges 32 by 32 deep boxed canvas 525 sold art2arts

santa maria della salute 32 by 40 deep boxed canvas 700

poppyfields2024 48 by 35 soldwith art2arts

amafi lemons 20 by 20 deep boxed canvas 250.00 in sold to customer in usa

mist over skye 36 by24 575 .00 sold

cragg rocks 20 by 28 35o pounds

lemons in ming bowl 20 by 24now 275.00 20 by 24

last days of summer 24 by 18 250 .00 sold with art2arts
sicilian lemons impressionistic oil painting with impasto sold with corner gallery august 2024

gardenia very chintz vintage floral 32 /32 inches
venetian gondola 48 by 32 / 122 cm by 80 cm on fine linen . 895 or ono

frosty morning sold to previous customer om artfinder

Morning Tide Sold with corner gallery

Blue Sunflowers 32 by 32 sold with art2arts to customer in belfast

daisy blue large panoramic floral piece 12 by 48 heavy deep boxed canvas 495 .00
mixed media daisy blue


Blue Sunrise . New painting on fine slim linen canvas subtle colours

studio picture of blue sunrise

Monet's Waterlilies 2024 New waterlily painting Deep boxed canvas 100 cm by 80 cm /40/32 695 .00

hollyhocks 24 by 30 inches on deep boxed fine linen canvas

where the wildflowers bloom . highly textured floral 40 /32 650 pounds


Portofino 32 by 40 /80 cm by 100 cm colourful oil painting of the iconic portofino , italy sold artgallery.co.uk

summer roses 2024 24 by 18 sale sold to customer on artfinder
island of elba 695 . 48 by 24

Elba Summertime 48 by 20 oil on canvas 650 sold to customer in gomshall with vintage frog

wild irises 2024 39.5 by 30 /100 cm by 76 sale 200
lavender in provence 2024 650 40 by 30 sale 300

Lemon Tree . Mixed Media / Sequins 100 cm by 100 cm
sold with art2arts


sold funky pink artgallery.co.uk

chrysanthemums in bloom 16 by 22 on linen canvas 150 .00
FUNKY PINK 40 BY 40 /100 cm by 100 cm bright coloured eclectic floral on deep boxed canvas 750 .00 sold today artgallery.co.uk

faraway dream sold with limehouseartgallery june 2024

FUNKY PINK

anenome pretty small floral on fine linen canvas 20 by 16 175 .00 fine linen

anemone in situ

little venice oil on canvas 20 by 22 fine linen 175 .00

camelia oil on deep boxed canvas 35 by 40 inches . sold with vintage frog august
morning tide new seascape 70 cm by 50 cm on linen canvas 20 by 28 slim linen canvas for sale in corner gallery 250
in my garden oil painting on deep boxed canvas 31.5 by 27.5 for sale 325 .00


seabreeze textured seascape 475 .00 40 by 29.5 sold at alresford with acvr

waterlilies 2024 475 . 40 by 31.5 sold with artgallery.co.uk

sold with art2arts 22/04/2024
Summer Violets Oil on canvas 28 by 28 / 70 cm by 70 cm 575 .00 pounds
poppy meadow 2024 39.5 by 39.5 colourful and ecletic 675.00
apple blossom lane . now for sale 325.00 pounds 20 by 27.5 on slim linen canvas

surreyhills artisan market 25 th feb
Faraway Dream

faraway dream 20 by 30 limehouse artgallery stalham 275 .00 pounds sold with limehouseartgallery stalham 1/06/2024

crab apple small oil painting 16 by 20 on linen canvas 175 .00

Daisy Meadow 2024 Impressionistic painting 40/40 700 .00 pounds sold

silver birch impressionistic painting 40/40 800.00 pounds available only through impressionistic painters.com


details of silver birch

daisy meadow
The Old Fisherman oil on canvas 30 /40

sweet valentine perfect valentine day gift . unique 29.5 by 20 inches . 450 pounds sold cranleigh
pink roses sold at cranleigh market

Summer 312024 Large floral piece 47 /31.5 sold with surrey hillenterprises 6th /7th april

lord of the isles 2024 oil on canvas 48 /30 Sold to customer in United States within 3 hours of going online

new painting the tulip bouquet 700 / 40/40 sold today 5 th may artgallery.co.uk



new iris painting very pretty . probably going on sale with corner galley this week in carlshalton
early one morning snowy scene 20 by 28 inches cards available

apple blossom lane 20 by 30 / 50 cm by 70 cm on fine hessain linen canvas cards available sold surrey hills enterprises

detail of painting irises

winter sunflowers 40 /40 sold to customer in germany art2arts


pink waterlilies now on line for sale 600 pounds 32 by 32 inches sold

summer meadow on sale in corner gallery in carlshalton beeches large canvas 48 /30 800 pounds sold now


red sky at night 47 by 31 .5 oil on canvas sold in alresford with acvr

The Kiss by Lesley Blackburn is now going online for sale now 1700 ono pounds beautiful bespoke frame very heavy in gold with purple inset . covered and decorated in sequins and pure gold leaf size of canvas 30 by 40 frame extra . very heavy frame on bespoke linen canvas
Purple rain 40 /40 oil on canvas
sold in farnham market 29/10/2023 purple rain



Isle of Mull . Contemporary Seascape . oil on canvas 48 by 30 panoramic sold 22/-04/2024 art2arts

Isle of Mull . Oil on deep boxed canvas sold wit art2arts

The Kiss by Lesley Blackburn in contemporary setting
cards available THe

The Kiss shown in different setting
some art critic thinks I have reproduced the original as if I would

Summer Meadow 2023 Large floral oil painting on deep boxed canvas
Wimbledon Exnibition Dates 5th September to 12 th September Private View 5th September 1 - 9 pm NormanPlastow Gallery Wimbledon Village Hall Lingfield road Wimbledon Village .For more information or book your place email lesleyblackburn5@gmail.com We are also showing work from the late pop artist simon fairless . Working in partnership with Corner Gallery in Carlshalton .We will be open everyday from 11- 8 . 12 september we will close early by 2 pm

Poppy Meadow 2023 Large Colourful impressionistic painting on deep boxed canvas

Golden Sunflowers Heavily textured and distressed sunflowers
In Limehouse Art Stalham Norfolk broads

Summer Meadow in situ

Detail of the Kiss by Lesley Blackburn

studio view its going to be available for sale in the wimbledon exhibition

This painting of the famous iconic image by Gustav klimt is spectacular . Its my version of it . Encrusted with Sequins ,copper and pure gold leaf . cards available 3.00 each or packs of 5 15.00

The Grand Canal Venice 40 by 32 Deep boxed canvas
Summer Bluebells 32 by 32 Oil on deep boxed canvas

so pretty impressionistic forget me knot 28 by 28 /70 cm for sale with corner gallery
now sold to customer in ewhurst surrey

The Lotus . Large Painting in oils . For wimbledon exhbition 40 /40 sold now by corner gallery in carlshalton
cards available 3.00 each

Fuschia Waterlilies 2023 Wimbledon Exhibition 5th to 12 Sept . Wimbledon Village Hall
Crimson Waterlilies is now sold to customer from walton on thames . Sold Framed for 1500 pounds . Frame by frame freak in Ewhurst
Tuscan Sunflower 2023 39 by 32 inches deep boxed canvas . 575.00 ono impressionistic and textured

studio image sold by artgallery.co.uk


Lily of the Valley 28 by 28 inches / 70 cm by 70 cm 650 .00 ono Deep boxed canvas .oil painting

Lily of the Valley Studio image

Studio image lily of the valley

The Flower Basket . Impressionistic florals on linen canvas 20 inches by 29.5 slim canvas .ready to hang 375 pounds sold to customer on artfinder 15/12/2023

studio image flower basket

Monet's Lily Pad 2023 This painting is still available for sale 32 by 40 on deep boxed canvas now on 1050 framed cards available 3.00 each in lime houseartgallery norfolk broads sold


The Lily Pad 60 cm by 60 cm 260 .00 pounds acrylic on deep boxed canvas


Cottage Garden 40 by 40
sold in guildford today 5/11/2023
acrylic floral impressionistic on deep boxed canvas 900 ono in corner gallery carlshalton
Sweet Magnolia , Impressionistic floral on slim linen canvas . 40 by 40 inches 550 pounds

Glorious Summer's Day by Lesley Blackburn 72 by 48 Price on application

poppies and daisies in pale blue frame . 350 .00 mixed media
cards for sale in this painting 3.00 each 5 for 15.00 to order

A Host of Golden Daffodils .40 BY 40 acrylic on canvas . 795.00 pounds
sold to customer at guildford artisan market 19/08/2023

Monets Waterlilies 2022 Sold by Corner Gallery in carlshalton 700.00 pounds
cards for sale in this painting 3.00 each or 15.00 for 5 to order


Monets waterlilies 2023 sold corner gallery carlshalton For 700 pounds

Summer Poppies 260 .00 60 cm by 60 cm
Sunflower Dreaming
Large panoramic impressionistic floral painting of sunflowers on deep boxed canvas . 48 by 24 inches / 120 cm by 60 cm . 600 pounds or ono . painted in acrylics and inks SOLD customer from Florida in United States

Bluebelle spring Sold to customer in germany
bluebelle Spring
Large Impressionistic painting on canvas . Ready to hang , Deep boxed canvas . 120 cm by 100 cm /48 by 40 inches . Painted in acrylics . 725 or ono
Summers Day
Large Statement Oil painting on deep boxed fine linen canvas . Beautiful Tulip Fields . 72 inches by 48 inches . image is for demonstration only as actual size of painting is as described . 180 cm by 120 cm Bespoke Linen canvas . Impressionistic in style
contact me lesley blackburn5@gmail.com
peonies oil on canvas . currently in corner gallery in carlshalton 325.00 pounds
sold by corner gallery carlshalton


sold in guildford market today 5/11/2023

Peonies Just Sold with Corner Gallery Carlshalton
in green vase 550 pounds oil on canvas available from corner gallery email lesleyblackburn5@gmail.com
